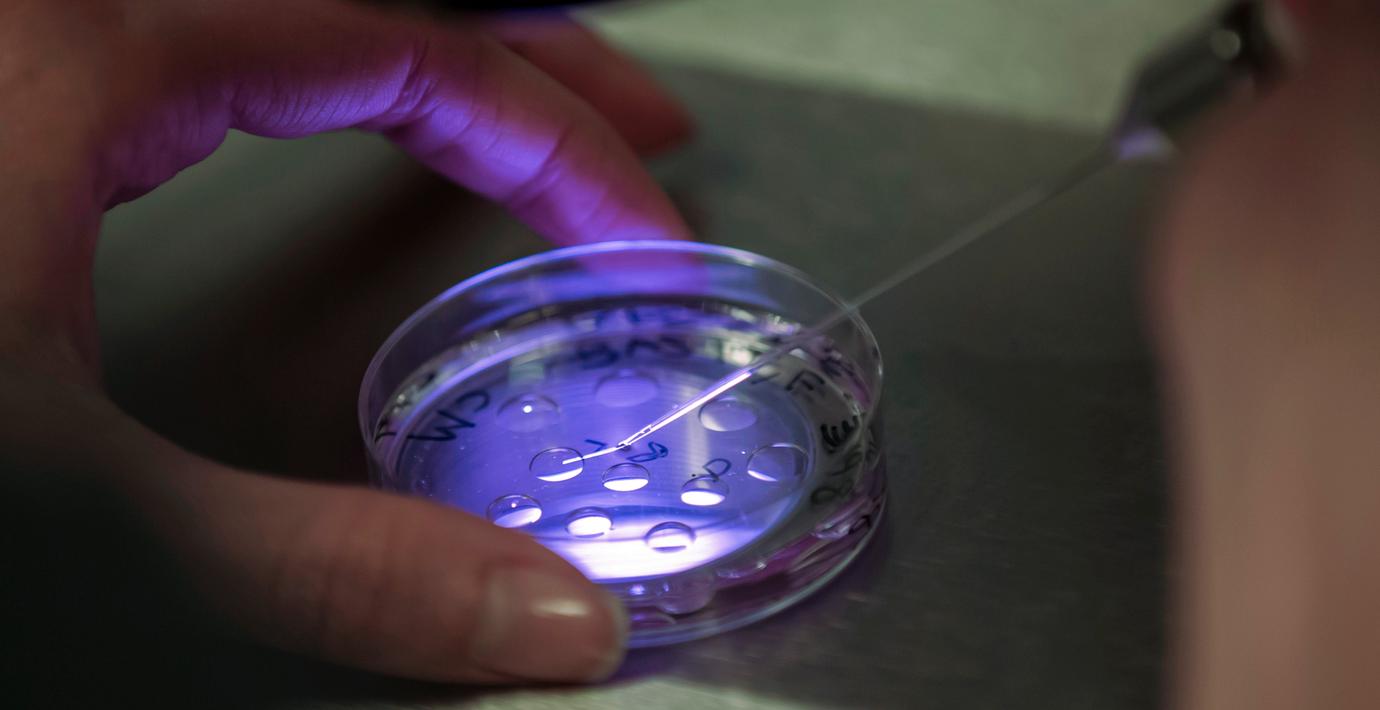

Spermieanalys ökar chanser att bli gravid
En ny studie av så kallad ICSI-behandling, som hjälper ofrivilligt barnlösa par, visar att det i vissa fall går att hoppa över vanlig IVF-behandling.
Skillnaden är att vid en IVF-behandling läggs en större mängd spermier i en skål som sedan själva får hitta fram till ägget – vid ICSI görs i stället först en analys av spermierna. En livsduglig spermie väljs sedan ut och förs med en nål in i ägget. Tillvägagångssättet ökar kraftigt chanserna att bli gravid i de fall där mannens spermier har en ovanligt stor andel kromosombrott.
– Man nästan fördubblar chansen till graviditet i dessa fall genom att använda den mer avancerade metoden, säger professor Aleksander Giwercman vid Skånes universitetssjukhus, till TT.
Omni är politiskt obundna och oberoende. Vi strävar efter att ge fler perspektiv på nyheterna. Har du frågor eller synpunkter kring vår rapportering? Kontakta redaktionen